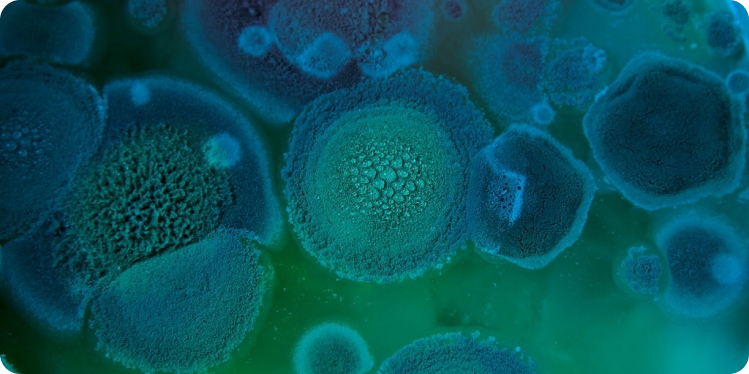

ANRUFEN
Rufen Sie uns gerne unverbindlich an und schildern Sie uns Ihr Anliegen.
BEGUTACHTUNG
Wir kommen schnellstmöglich zu Ihnen, um alle wichtigen Messungen und Untersuchungen vorzunehmen.
GUTACHTENERSTELLUNG
Nach der Aufnahme aller Werte erstellen wir Ihnen zeitnah das Gutachten und lassen es Ihnen zukommen.

Die Ursachen von Baumängeln und Bauschäden sind oft komplex und ohne einen Bausachverständigen schwer zu ermitteln. Ein Haus ist ein handwerkliches Unikat, beeinflusst durch zahlreiche Gewerke, Materialien und individuelle Planung und Nutzung. Baumängel entstehen, wenn das Gebäude nicht den vertraglichen Vereinbarungen oder technischen Normen entspricht. Diese Schäden beeinträchtigen nicht nur Optik und Funktion, sondern können auch die Bausubstanz schädigen. Ein Bausachverständiger bietet neutrale und fachkundige Ursachenanalyse, um den Schaden zu begrenzen und dem Bauherrn Sicherheit bei der Schadensbeseitigung zu bieten.
Schimmelpilz in Gebäuden ist nicht nur ein optisches Problem, sondern kann auch gesundheitsschädlich sein und die Bausubstanz sowie den Immobilienwert mindern. Ein Bausachverständiger untersucht schnell und effizient die betroffenen Stellen, identifiziert die Ursachen. Durch sein Fachwissen werden kostspielige und ineffektive Sanierungen vermieden. Wichtige Erstmaßnahmen wie das Stoppen der Sporenverbreitung und der Einsatz qualifizierter Fachbetriebe minimieren den Schaden und sichern eine vollständige Behebung. Auch nach der Sanierung überprüft der Gutachter den Erfolg und berät weiterhin, um zukünftigen Schimmelbefall zu verhindern.

Beim Kauf eines Hauses oder einer Eigentumswohnung bietet eine professionelle Beratung durch unsere unabhängigen Bausachverständigen eine solide Entscheidungsgrundlage. Vor der Besichtigung prüft der Sachverständige die vorhandenen Unterlagen und bereitet sich durch eine Marktwerteinschätzung vor. Gemeinsam wird das Objekt vor Ort begangen, um den baulichen Zustand und eventuellen Sanierungsbedarf festzustellen. Der Baugutachter beantwortet Ihre spezifischen Fragen, etwa zu Umbaumaßnahmen. Nach der Besichtigung erläutert der Bausachverständige alle relevanten Fakten klar und verständlich, wodurch Sie Ihre Kaufentscheidung sicher treffen können.

Die baubegleitende Qualitätssicherung durch einen Bausachverständigen bietet neutrale Kontrolle und erhöht die Qualität beim Bau oder Umbau einer Immobilie. Angesichts des Kostendrucks in der Baubranche sichert der Baugutachter die Übereinstimmung von Baubeschreibung, Planung und Ausführung. Bereits vor Vertragsunterzeichnung sollte der Bausachverständige die Bauunterlagen prüfen, um Planungsfehler zu verhindern. Er bietet eine umfassende Prüfung der Dokumente und eine Erstbesichtigung des Grundstücks an. Nach Baubeginn erfolgen regelmäßige Baustellentermine nach wichtigen Bauabschnitten, wie dem Rohbau oder vor dem Innenputz, um Arbeiten zu inspizieren und Qualität und Sicherheit für ihr zukünftiges Zuhause zu gewährleisten.

Eine Energieberatung durch einen zertifizierten Energieberater bietet einen Überblick über Modernisierungsmaßnahmen und Fördermöglichkeiten für Ihre Immobilie. Die Berater sind objektiv und zeigen, welche Maßnahmen sofort umsetzbar sind und welche später angegangen werden können. Sie berücksichtigen auch die spezifischen Gegebenheiten Ihrer Immobilie. Da viele weniger über den Energiebedarf von Immobilien wissen, ist ein Energieausweis für Verkauf und Vermietung gesetzlich erforderlich. Energieberater unterstützen bei der Erstellung des Energieausweises und geben eine energetische Einschätzung beim Immobilienkauf.

Die Immobilienbewertung durch einen zertifizierten Sachverständigen liefert eine fundierte Einschätzung des Wertes Ihrer Immobilie, basierend auf aktuellen Marktbedingungen und individuellen Eigenschaften des Objekts. Unsere Sachverständigen agieren neutral und objektiv, um Ihnen transparent zu zeigen, welche Faktoren den Wert Ihrer Immobilie beeinflussen. Sie berücksichtigen dabei Aspekte wie Lage, Zustand, Baujahr und Ausstattung der Immobilie. Die objektive Bewertung ist beim Verkauf, Kauf oder bei der Finanzierung von Immobilien wichtig, um sicherzustellen, dass alle Beteiligten eine klare Vorstellung vom realen Wert der Immobilie haben. Ein professionell erstelltes Gutachten hilft, fundierte Entscheidungen zu treffen.

Baucampus ist eine renommierte Plattform in Europa, die sich auf Baubegleitung, Bauschadensbewertung, Energieberatung, Hauskaufberatung, Immobilienbewertung und die Begutachtung von Schimmelpilzen spezialisiert hat. Unter der Leitung von Oskar Lohse, dem Chief Executive Officer, vereint Baucampus ein beeindruckendes Netzwerk von über 70 Bauexperten aus verschiedenen Bereichen.
Die Dienstleistungen von Baucampus richten sich an Bauherren, Immobilienkäufer und -besitzer, die professionelle Unterstützung bei der Bewertung und Optimierung ihrer Immobilien suchen. Durch die umfassende Expertise in verschiedenen Fachgebieten bietet Baucampus seinen Kunden eine qualitativ hochwertige Beratung, die darauf abzielt, langfristige Lösungen und Verbesserungen für bauliche Anliegen zu schaffen.
Die Plattform ist nicht nur ein Zusammenschluss von Fachleuten, sondern auch eine Quelle für Marktberichte und aktuelle Informationen im Bauwesen, die Interessenten helfen, informierte Entscheidungen zu treffen. Mit einem starken Fokus auf Qualität und Kundenzufriedenheit hat sich Baucampus als vertrauenswürdiger Partner im europäischen Bausektor etabliert.

Das Bausachverständigen Netzwerk Baucampus steht für eine zukunftsorientierte Initiative, die Fachwissen und branchenspezifische Kompetenzen im Bauwesen bündelt. Ziel des Netzwerks ist es, durch Kooperationen zwischen Sachverständigen, Ingenieuren und Architekten die Qualität und Effizienz von Bauprojekten zu steigern und innovative Lösungen für die Bauindustrie zu fördern.
Gegründet mit der Vision, ein führendes Forum für den Austausch von Fachwissen im Bauwesen zu schaffen, bietet Baucampus eine Plattform, auf der sich Experten aus verschiedenen Disziplinen vernetzen, gemeinsam Projekte entwickeln und Best Practices austauschen können. Die Mitglieder des Netzwerks kommen aus verschiedenen Bereichen wie Baurecht, Bauingenieurwesen, Architektur und Umwelttechnik, wodurch ein umfassender Wissensaustausch und interdisziplinäre Zusammenarbeit ermöglicht wird.
Das Bausachverständigen Netzwerk Baucampus ist nicht nur eine Wissensbasis für seine Mitglieder, sondern auch eine beratende Instanz für externe Auftraggeber, einschließlich privater Bauherren, Unternehmen und öffentlicher Einrichtungen. Durch seine Expertise trägt Baucampus dazu bei, dass Bauprojekte erfolgreich, nachhaltig und gesetzeskonform umgesetzt werden.
In einer Branche, die ständigem Wandel unterliegt und zunehmend komplexe Anforderungen stellt, erweist sich das Bausachverständigen Netzwerk Baucampus als unverzichtbarer Partner für Qualität und Innovation im Bauwesen.

Das Bausachverständigen Netzwerk Baucampus hat sich als eine führende Initiative in Deutschland etabliert, die darauf abzielt, die Qualität und Sicherheit im Bauwesen durch den Austausch von Fachwissen und die Vernetzung von Experten zu verbessern. Gegründet mit der Vision, ein umfassendes Unterstützungsnetzwerk für Bauvorhaben aller Art zu bieten, bringt Baucampus erfahrene Bauingenieure, Architekten, Techniker und weitere Fachleute zusammen.
Das Hauptziel von Baucampus ist es, die Baubranche durch die Bereitstellung eines robusten Netzwerks von qualifizierten Sachverständigen zu stärken. Diese Experten bieten unabhängige Beratung und Überprüfung von Bauprojekten, um sicherzustellen, dass alle technischen und regulatorischen Standards eingehalten werden. Durch regelmäßige Schulungen und Weiterbildungen hält Baucampus seine Mitglieder stets auf dem neuesten Stand der Technik und aktueller gesetzlicher Regelungen.
Der Baucampus trägt erheblich zur Verbesserung der Bausicherheit und -qualität bei, indem er sicherstellt, dass Bauvorhaben nicht nur den aktuellen Bauvorschriften entsprechen, sondern auch zukunftsorientierte Lösungen und nachhaltige Praktiken berücksichtigen. Dies ist besonders in Zeiten des Klimawandels und der Urbanisierung von entscheidender .